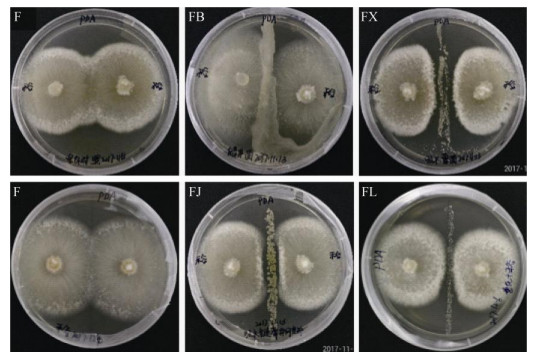

2. 中国科学院大学, 北京 100049
以禾谷镰刀菌(Fusarium graminearum)为主要致病菌引发的小麦赤霉病是世界性的流行病害,多发生在温暖潮湿的区域,具有周期性流行的特点[1-3]。中国的小麦赤霉病发病面积为全球最大,其在淮河以南及长江中下游麦区发生最为严重,华南和东北麦区经常流行成灾;随着秸秆还田普及、灌溉面积扩大及全球气候变暖,小麦赤霉病已逐渐向西北扩展至黄淮海冬麦区[4-5]。赤霉病不仅会大幅度降低小麦的产量和品质,其病原菌代谢产生的真菌毒素也会对人畜健康造成严重威胁[3, 6]。因此,有关小麦赤霉病的防治工作一直备受关注。
目前小麦赤霉病的防控措施主要包括抗病品种选育、化学药剂防治和生物防治[3, 7-8]。选育抗赤霉病的小麦品种是最直接的赤霉病控制方式,但因赤霉病抗原较少且抗性机制较为复杂[9],致使抗病且适宜大面积推广种植的小麦种质资源严重缺乏。化学药剂防治是减轻小麦赤霉病发生程度的关键,然而却容易导致病原菌产生抗药性并对环境造成污染[7]。近年来,利用拮抗微生物及其代谢产物的生物防治措施因具有安全、低毒且对环境友好等优势,已成为赤霉病防控的研究焦点[8, 10-11]。链霉菌(Streptomyces spp.)和芽胞杆菌(Bacillus spp.)作为防治赤霉病重要的两类生防菌,能分泌产生抗生素、环脂肽等多种具有抑菌作用的次级代谢产物,对禾谷镰刀菌的生长具有明显的抑制作用[12-14]。然而,目前有关小麦赤霉病生物防治的研究多聚焦于生防菌的分离筛选和鉴定[10, 12, 14],忽略了实际生产中秸秆的存在对小麦赤霉病爆发的影响。
秸秆还田是目前农业生产中秸秆资源利用的主要渠道,但其为各种病原生物的存活和增殖提供了有利环境条件,加剧了农田作物病虫害的发生。禾谷镰刀菌在田间的生长基质主要为秸秆,其是引起小麦赤霉病爆发的关键源头之一。Trail[15]和Leplat等[16]曾系统介绍了小麦赤霉病菌侵染循环过程,强调了病原菌通常以田间秸秆为基质进行越夏越冬,其在秸秆残体上形成的子囊壳或分生孢子是下一季度赤霉病爆发的初侵染源。因此筛选秸秆降解生防菌加快田间秸秆降解,控制秸秆源头的病原菌数量对小麦赤霉病的防控具有重要意义。目前秸秆降解过程中拮抗菌对小麦赤霉病菌的拮抗效应是否与平板对峙获取的结果一致尚不清楚,有关赤霉病菌在秸秆中的生长规律也尚未见报道。本文以禾谷镰刀菌为研究对象,结合平板对峙试验和室内培育试验,探究秸秆降解过程中禾谷镰刀菌的动态消长规律及其如何受制于生防拮抗菌,以期为小麦赤霉病的生物防治和生防产品开发提供理论指导。
1 材料与方法 1.1 供试材料供试秸秆为玉米秸秆,于2017年10月采自中国科学院封丘农业生态试验站(114° 24' E,35° 00' N)。将采集到的新鲜玉米秸秆洗净后于65 ℃烘干至恒重,经粉碎机粉碎后过60目筛备用。秸秆基本理化性质为:全碳489.19 g/kg、全氮10.17 g/kg、全磷1.24 g/kg、全钾15.87 g/kg。
供试禾谷镰刀菌(F. graminearum,菌株编号为CGMCC3.4598) 购自中国普通微生物菌种保藏中心(CGMCC)。所选禾谷镰刀菌拮抗菌株为蜡状芽胞杆菌(B. cereus,菌株编号为ACCC10263)、吸水链霉菌(S. hygroscopicus,菌株编号为ACCC41648)、吸水链霉菌井冈变种(S. hygroscopicus var. jingganggensis,菌株编号为ACCC40051) 和娄彻氏链霉菌(S. rochei,菌株编号为ACCC41594),上述4种菌株购自中国农业微生物菌种保藏管理中心(ACCC)。
1.2 试验设计 1.2.1 平板对峙试验采用对峙培养法初步检验4种拮抗菌对禾谷镰刀菌生长的抑制作用。先用接种环将活化后的4种拮抗菌在直径为90 mm的PDA培养基中央竖直划一条菌带,再用打孔器截取直径为7 mm的禾谷镰刀菌菌饼,分别接种于拮抗菌菌带两侧,要求两菌饼中心各距菌带中心20 mm。以只接种禾谷镰刀菌的平板为对照,每个处理重复3次。最后将平板置于25 ℃恒温避光培养7 d,测量抑菌带宽度。抑菌带宽度为拮抗菌菌带边缘到禾谷镰刀菌菌落边缘的垂直距离。
1.2.2 室内培育试验试验共设置4个处理,即玉米秸秆+禾谷镰刀菌(SF,对照)、玉米秸秆+禾谷镰刀菌+吸水链霉菌(SFX)、玉米秸秆+禾谷镰刀菌+吸水链霉菌井冈变种(SFJ)、玉米秸秆+禾谷镰刀菌+娄彻氏链霉菌(SFL),每个处理重复3次。具体试验步骤:称取过60目筛的烘干玉米秸秆样品10.0 g于1000 ml无菌塑料瓶内,加入无菌水至秸秆饱和吸水。按照表 1设计的菌剂接种量,先加入禾谷镰刀菌分生孢子悬液至玉米秸秆,25 ℃恒温避光培养12 h以促其孢子萌发成新的菌丝后,再向秸秆中加入上述3种拮抗链霉菌菌液。随后将盛有15 ml 1 mol/L NaOH溶液的25 ml吸收杯小心悬挂于塑料瓶内,加盖密封,在25 ℃条件下恒温避光培养70 d,同时设置空白对照,培养期间及时补充无菌水以维持秸秆饱和吸水。分别在培养的第7、42和70天时进行破坏性采样,以测定禾谷镰刀菌丰度和残留秸秆养分含量。玉米秸秆的碳矿化量则采用碱液吸收法测定,分别在培养的第1 ~ 14天和第19、24、29、34、39、42、51、59和70天,取出盛有碱液的吸收杯,用浓度为1 mol/L HCl标准溶液进行滴定,计算CO2-C释放量。
|
|
表 1 供试玉米秸秆接种菌量 Table 1 Inoculation concentrations of different microbes in maize straws |
玉米秸秆理化性质测定采用常规土壤农化分析方法[17]:秸秆全碳含量采用重铬酸钾–外加热法测定;全量氮磷钾采用H2SO4-H2O2消煮法,用半微量凯氏定氮法测定全氮含量,钼锑抗比色法测定全磷含量,火焰光度计法测定全钾含量。
1.3.2 禾谷镰刀菌丰度测定残留秸秆中的禾谷镰刀菌丰度采用荧光染料(SYBR Green) 渗入法进行实时荧光定量PCR (qPCR)。所选用于定量禾谷镰刀菌的特异性引物为Fg16F/Fg16R (Fg16F: 5′- CTCCGGATATGTTGCGTCAA-3′, Fg16R: 5′-GGTA GGTATCCGACATGGCAA-3′)[18]。采用宝生物工程(大连)有限公司提供的SYBR Premix Ex TaqTM试剂盒,用CFX96 Real-Time PCR System扩增仪(Bio-Rad,美国)分析,每个样品平行3次。qPCR反应体系(25 μl) 包括SYBR Premix Ex TaqTM 12.5 μl,上、下游引物(10 μmol/L) 各0.3 μl,DNA模板2 μl,灭菌双蒸水9.9 μl。qPCR扩增条件[19]为95 ℃、2 min,然后95 ℃、15 s,60 ℃、30 s,72 ℃、45 s,40个循环,于72 ℃时测定荧光值。qPCR标准曲线建立:从纯培养的禾谷镰刀菌中提取菌丝DNA并测定其浓度(ng/μl),将菌丝DNA样品按10倍比稀释制作7个浓度梯度(10 ~ 10-5 ng/μl) 系列标准样品,标准样品与待测样品在相同反应条件下进行实时荧光定量PCR扩增,根据标准样品Ct值与浓度梯度构建标准曲线。最后将得到的待测样品Ct值代入标准曲线,计算禾谷镰刀菌丰度。
1.3.3 数据计算与方程拟合| $ \begin{array}{l}{\rm{玉米秸秆}}{\text{CO}}_{2}-\text{C}{\rm{释放量}}(\text{g/kg})=\\ \frac{({V}_{0}-{V}_{1})\times {C}_{HCl}}{2}\times 44\times \frac{12}{44}\times \frac{1}{m}\end{array} $ |
式中:CHCl为标准盐酸浓度(mol/L);V0为空白滴定消耗的盐酸体积(ml);V1为样品滴定消耗的盐酸体积(ml);m为烘干玉米秸秆质量(g)。
玉米秸秆CO2-C累积释放量(g/kg) 指从培养开始到某一时间点秸秆CO2-C的总释放量。本研究采用一级动力学方程[20]对秸秆CO2-C累积释放量进行拟合,即Ct = C0 (1–e–kt) + C1,式中Ct为培养时间t (d) 时的CO2-C累积释放量(g/kg),C0和k分别表示秸秆潜在可矿化碳含量(g/kg) 及其矿化速率常数(d–1),C1表示秸秆易矿化碳含量(g/kg)。
1.4 数据处理试验数据采用SPSS 21.0进行单因素方差分析(One-way ANOVA)和邓肯(Duncan)显著性检验,比较不同处理在P < 0.05水平的显著性差异。采用Origin 9.0作图,SigmaPlot 13.0进行秸秆碳矿化动力学方程拟合和参数计算。
2 结果 2.1 平板对峙试验由平板对峙结果(图 1)可知,供试4种拮抗菌株对禾谷镰刀菌CGMCC3.4598菌丝生长的抑制效果不同。蜡状芽胞杆菌ACCC10263未对病原菌株CGMCC3.4598表现抑制作用,而吸水链霉菌ACCC41648、吸水链霉菌井岗变种ACCC40051和娄彻氏链霉菌ACCC41594对病原菌菌丝的生长均有不同程度的抑制作用,经测量其抑菌带平均宽度依次为2.67、1.67和1.12 mm,初步表明供试的这3种链霉菌菌株为禾谷镰刀菌CGMCC3.4598的潜在拮抗菌。
|
(F:禾谷镰刀菌CGMCC3.4598;FB、FX、FJ和FL分别表示禾谷镰刀菌CGMCC3.4598与蜡状芽胞杆菌ACCC10263、吸水链霉菌ACCC41648、吸水链霉菌井冈变种ACCC40051和娄彻氏链霉菌ACCC41594的平板对峙) 图 1 4种拮抗菌株对禾谷镰刀菌CGMCC3.4598的抑制作用 Fig. 1 Antifungal activities of four antagonistic strains against F. graminearum CGMCC3.4598 |
在为期70 d的室内培育试验中,残留秸秆中的禾谷镰刀菌CGMCC3.4598丰度随着培养时间的延长呈先增加后降低并趋于消亡的动态变化规律(图 2)。各处理残留秸秆中的禾谷镰刀菌丰度在秸秆降解42 d时达到最大值,为25.08 ~ 120.92 ng/g,而培养结束(70 d) 时,各处理残留秸秆中的禾谷镰刀菌丰度处于最低水平,仅有0.90 ~ 11.74 ng/g。

|
(图中小写字母不同表示同一培养期不同处理间的差异显著(P < 0.05),下同) 图 2 残留玉米秸秆中的禾谷镰刀菌CGMCC3.4598丰度 Fig. 2 F. graminearum CGMCC3.4598 abundance in residual maize straws |
对比不同处理来看,秸秆降解7 d时,残留秸秆中的禾谷镰刀菌丰度顺序为SFX > SFJ > SF > SFL,其中SFL处理的禾谷镰刀菌丰度较SF处理显著降低30.91%,而SFX和SFJ处理的禾谷镰刀菌丰度则分别较SF处理显著提高582.78% 和168.69% (P < 0.05)。秸秆降解42 d时,残留秸秆中的禾谷镰刀菌丰度顺序为SFJ≥SF≥SFX > SFL,该时期SFL处理的禾谷镰刀菌丰度为25.08 ng/g,较SF处理显著降低69.28%,而SFX和SFL处理与SF相比无显著性差异。秸秆降解末期(70 d),SF和SFL处理的残留秸秆中的禾谷镰刀菌均已近乎消亡(< 1.00 ng/g),两处理间无显著性差异,而SFX和SFJ处理的禾谷镰刀菌丰度较SF处理则分别提高约1倍和10倍(P < 0.05)。总结上述结果可知,秸秆降解7、42和70 d后,吸水链霉菌ACCC41648及其井冈变种ACCC40051均未能显著降低禾谷镰刀菌CGMCC3.4598在残留秸秆中的丰度,而娄彻氏链霉菌ACCC41594在秸秆降解7 d和42 d后显著降低秸秆中的禾谷镰刀菌丰度分别达30.91% 和69.28%。
2.3 拮抗链霉菌对秸秆矿化特征的影响不同处理玉米秸秆CO2-C累积释放量的变化规律相同,均呈前期(0 ~ 14 d) 增速较快,随着培养时间延长而增幅减缓并逐渐走向平稳的趋势(图 3)。秸秆降解的前14 d,各处理秸秆CO2-C累积释放量在22.54 ~ 24.77 g/kg,占培养结束时(70 d) 秸秆CO2-C累积释放量的50.98% ~ 52.38%,表明玉米秸秆在培养初期的矿化过程剧烈。对比不同处理来看,秸秆降解7、42和70 d后,SFL处理的秸秆CO2-C累积释放量均达到最大,分别较不添加任何拮抗链霉菌的对照(SF)显著提高11.07%、11.58% 和12.12% (P < 0.05),而SFX和SFJ处理的CO2-C累积释放量与SF处理相比均无显著差异,该结果表明娄彻氏链霉菌ACCC 41594的添加对玉米秸秆的降解有显著促进作用。

|
图 3 不同处理的CO2-C累积释放量 Fig. 3 Cumulative emission amounts of CO2-C under different treatments |
为了进一步研究玉米秸秆降解过程中碳组分含量的变化,采用一级动力学方程(Ct = C0 (1–e–kt) + C1)[20]对秸秆CO2-C累积释放量与培养天数之间的动态变化进行拟合,并计算其矿化参数,结果发现该方程能很好地描述秸秆碳矿化动态过程(拟合优度R2 ≥0.994)。如表 2所示,各处理的秸秆潜在可矿化碳(C0)含量(40.21 ~ 43.63 g/kg)远高于易矿化碳(C1)含量(2.83 ~ 4.33 g/kg),C0约为C1的9.74倍~ 15.41倍。对比不同处理来看,C0在各个处理之间没有显著性差异,而C1则呈现SF≈SFJ > SFX≈SFL的变化规律,其中SFX和SFL处理的C1与SF处理相比分别显著降低23.10% 和25.72% (P < 0.05)。对于矿化速率常数(k)而言,SFX、SFJ和SFL处理与SF相比均无显著性差异。
|
|
表 2 根据一级动力学方程计算得到的秸秆碳矿化参数值 Table 2 Estimated parameters according to first order kinetic equation for mineralization of maize straw carbon |
表 3结果显示,秸秆降解7 d时,添加拮抗链霉菌处理的残留秸秆全碳含量分别较不添加任何拮抗菌的对照(SF) 显著降低2.56%、3.69% 和3.69%,而秸秆全磷和C/P与对照相比无显著差异;此外,该时期SFX处理的秸秆全钾含量和SFL处理的全氮含量较SF处理分别显著降低4.00% 和7.97%,SFJ处理的秸秆C/N和C/K则显著低于SF处理。秸秆降解42 d时,残留秸秆的全碳、全钾、C/N和C/K在不同处理之间均无显著性差异;添加拮抗链霉菌处理的残留秸秆全磷含量均显著高于对照,C/P则显著低于对照。秸秆降解70 d时,不同处理之间残留秸秆的全碳、全磷和C/P无显著性差异;就秸秆其他养分指标而言,SFJ处理的残留秸秆全氮含量显著最高,C/N显著最低,而SFL处理的残留秸秆全氮含量和C/N的变化规律与SFJ处理相反。
|
|
表 3 残留玉米秸秆的养分性质 Table 3 Nutrient characteristics of residual maize straws |
从整个培养阶段来看,秸秆降解7、42和70 d后,各处理残留秸秆的全碳和全氮含量均呈先增加后降低的变化趋势,而残留秸秆的其他养分指标随着培养时间延长尚无明显的变化规律。
2.5 禾谷镰刀菌CGMCC3.4598丰度与残留秸秆性质的相关性由表 4的相关性分析结果可知,秸秆降解7 d时,残留秸秆中的禾谷镰刀菌CGMCC3.4598丰度与秸秆全钾含量极显著负相关(P < 0.01);降解42 d时,残留秸秆中的禾谷镰刀菌丰度与秸秆易矿化碳(C1)含量显著正相关(P < 0.05);降解70 d时,禾谷镰刀菌丰度与秸秆全氮含量极显著正相关(P < 0.01),与C/N极显著负相关(P < 0.01)。
|
|
表 4 禾谷镰刀菌CGMCC3.4598丰度与残留秸秆性质的相关性(n = 12) Table 4 Correlation coefficients among F. graminearum CGMCC3.4598 abundance with properties of residual maize straws |
通过平板对峙试验对4种生防菌株的拮抗效果进行初步检验(图 1),确定了吸水链霉菌ACCC41648 (S. hygroscopicus)、吸水链霉菌井冈变种ACCC40051 (S. hygroscopicus var. jingganggensis)和娄彻氏链霉菌ACCC41594(S. rochei)为禾谷镰刀菌CGMCC3.4598 (F. graminearum)的潜在拮抗菌,这与前人[21-22]的研究结果相似。有研究认为蜡状芽胞杆菌(B. cereus)作为生防芽胞杆菌的一种,能分泌抗菌肽等多种抑菌活性物质,对小麦赤霉病菌有明显的抑制作用[23]。但从本研究的对峙结果来看,蜡状芽胞杆菌ACCC 10263对病原菌株CGMCC3.4598的生长未表现拮抗作用,其原因有待进一步研究。基于70 d的室内培育试验,我们发现秸秆降解7、42和70 d后(图 2),吸水链霉菌ACCC41648及其井冈变种ACCC40051均未表现抑制残留秸秆中禾谷镰刀菌生长的效应,这与本文平板对峙呈现的结果不一致;而娄彻氏链霉菌ACCC41594在秸秆降解前42 d降低秸秆中的禾谷镰刀菌丰度达30.91% ~ 69.28%,其拮抗效果较上述两种链霉菌株更为稳定。以上结果表明由平板对峙筛选得到的拮抗菌株在其他环境条件下不一定能很好地复现其拮抗作用。即便这些菌株在离体拮抗试验中对目标病原菌产生较强的拮抗作用,但在实际病害防治试验中可能没有防效[24],这在前人[25-26]研究结果中得到了证实。然而也有不少研究表明,经平板对峙筛选获得的拮抗菌株在室内培养、盆栽试验和大田试验中均表现出相同的生防效果[27-29],其拮抗潜力依旧稳定存在。Weller[30]研究认为拮抗菌在不同环境条件下对目标病原菌所表现的防效差异可能与其自身的生存能力、定殖能力以及抑菌物质的产生能力等密切相关。
3.2 拮抗链霉菌介导下的秸秆降解对禾谷镰刀菌CGMCC3.4598消长的影响根据室内培育试验结果(图 2),我们发现无论拮抗链霉菌添加与否,秸秆降解42 d是禾谷镰刀菌CGMCC3.4598从旺盛生长转向衰亡的临界期;秸秆降解末期(70 d),残留秸秆中的禾谷镰刀菌丰度已降至最低水平。引起这种变化的原因可能是在培养前期,秸秆含有的可溶性糖、氨基酸等营养物质相对充足,禾谷镰刀菌CGMCC3.4598能利用这些养分迅速扩繁,随着秸秆不断降解,残留秸秆中的易利用养分逐渐被消耗殆尽,病原菌因有效养分供应不足而最终走向消亡[31]。
本研究发现娄彻氏链霉菌ACCC41594对禾谷镰刀菌CGMCC3.4598的拮抗效果更稳定,其在秸秆降解7 d和42 d时降低的禾谷镰刀菌丰度分别达30.91% 和69.28%。尽管秸秆降解70 d时,添加娄彻氏链霉菌ACCC41594处理的禾谷镰刀菌丰度与对照(SF)相比无显著差异(图 2),但该时期对照组残留秸秆中的禾谷镰刀菌已近乎消亡,其丰度仅有0.90 ng/g左右,我们推测目标病原菌丰度过低很可能是导致该时期娄彻氏链霉菌ACCC41594拮抗效应不显现的原因之一。另外,从秸秆CO2-C累积释放量的结果来看(图 3),添加娄彻氏链霉菌ACCC41594能显著促进玉米秸秆的降解(图 3),这与前人[32-33]的研究结果一致,他们认为娄彻氏链霉菌是一种纤维素降解放线菌,其可产纤维素酶等胞外水解酶分解纤维素和木质素类物质,对农作物秸秆的腐解作用十分明显。进一步研究发现,该拮抗菌株较对照显著降低了秸秆易矿化碳(C1)含量(表 3),上述结果暗示娄彻氏链霉菌ACCC41594很可能以消耗更多易矿化碳的形式促进了玉米秸秆的降解,其原因有待进一步研究。为了探明拮抗链霉菌添加后的秸秆性质变化与禾谷镰刀菌丰度之间的关系,本文发现秸秆降解7 d时,添加娄彻氏链霉菌ACCC41594较对照显著降低了秸秆的全碳、全氮和C/K(表 4),但相关性分析结果(表5)显示残留秸秆中的禾谷镰刀菌丰度与上述指标无显著相关,这暗示了该时期娄彻氏链霉菌ACCC41594抑制病原菌株CGMCC3.4598生长的效应有可能来自其直接拮抗作用。周淑霞[33]和Han等[34]研究表示娄彻氏链霉菌可产生多种具有抑菌作用的胞外次生代谢产物,能直接对禾谷镰刀菌菌丝的生长产生抑制作用。秸秆降解42 d时,残留秸秆中的禾谷镰刀菌丰度与秸秆易矿化碳含量显著正相关(P < 0.05),易矿化碳是容易被微生物降解利用的碳组分[35-36],其活性较高,当秸秆易矿化碳含量减少时,会引起赤霉病菌生长所需的活性有机碳供应不足,进而限制了其生长繁殖。因此该时期娄彻氏链霉菌ACCC41594对残留秸秆中禾谷镰刀菌生长产生的抑制效应可能是通过竞争消耗了更多的秸秆易矿化碳,引起病原菌所需的易利用碳源减少所致。综合上述讨论可知,娄彻氏链霉菌ACCC41594在秸秆降解过程中抑制禾谷镰刀菌CGMCC3.4598生长的效应有可能通过其直接拮抗作用,也有可能通过促进秸秆降解引起残留秸秆的性质发生变化所致,其机制仍有待进一步研究。
4 结论本研究先通过平板对峙试验确定了吸水链霉菌ACCC41648、吸水链霉菌井冈变种ACCC40051和娄彻氏链霉菌ACCC41594是禾谷镰刀菌CGMCC 3.4598的潜在拮抗菌。然后基于70 d的室内培育试验,发现秸秆降解7、42和70 d后,娄彻氏链霉菌ACCC41594的拮抗效果较上述两株拮抗链霉菌更为稳定,其能直接抑制禾谷镰刀菌的生长,也能在促进秸秆降解的过程中通过改变残留秸秆性质间接抑制禾谷镰刀菌的生长。本研究结果为小麦赤霉病的生物防治提供了一定的理论指导。
| [1] |
小麦赤霉病发生危害形势及防控对策[J]. 植物保护, 2017, 43(5): 11-17 DOI:10.3969/j.issn.0529-1542.2017.05.002 (  0) 0) |
| [2] |
中国小麦赤霉病的危害及抗性遗传改良[J]. 江苏农业学报, 2012, 28(5): 938-942 (  0) 0) |
| [3] |
Dweba C C, Figlan S, Shimelis H A, et al. Fusarium head blight of wheat: Pathogenesis and control strategies[J]. Crop Protection, 2017, 91: 114-122 DOI:10.1016/j.cropro.2016.10.002 (  0) 0) |
| [4] |
小麦抗赤霉病研究现状与展望[J]. 遗传, 2018, 40(10): 858-873 (  0) 0) |
| [5] |
2018年我国小麦赤霉病重发特点及原因分析[J]. 植物保护, 2019, 45(2): 160-163 (  0) 0) |
| [6] |
Bönnighausen J, Schauer N, Schäfer W, et al. Metabolic profiling of wheat Rachis node infection by Fusarium graminearum - decoding deoxynivalenol-dependent susceptibility[J]. The New Phytologist, 2019, 221(1): 459-469 DOI:10.1111/nph.15377 (  0) 0) |
| [7] |
我国小麦赤霉病发生与控制研究进展[J]. 河北农业科学, 2020, 24(2): 54-58 (  0) 0) |
| [8] |
小麦赤霉病生物防治研究进展[J]. 江苏农业科学, 2020, 48(4): 12-18 (  0) 0) |
| [9] |
Anand A, Zhou T, Trick H N, et al. Greenhouse and field testing of transgenic wheat plants stably expressing genes for thaumatin-like protein, chitinase and glucanase against Fusarium graminearum[J]. Journal of Experimental Botany, 2003, 54(384): 1101-1111 DOI:10.1093/jxb/erg110 (  0) 0) |
| [10] |
Kemp N D, Vaughan M M, McCormick S P, et al. Sarocladium Zeae is a systemic endophyte of wheat and an effective biocontrol agent against Fusarium head blight[J]. Biological Control, 2020, 149: 104329 DOI:10.1016/j.biocontrol.2020.104329 (  0) 0) |
| [11] |
小麦赤霉病的防治技术研究进展[J]. 中国植保导刊, 2014, 34(1): 24-28, 53 DOI:10.3969/j.issn.1672-6820.2014.01.005 (  0) 0) |
| [12] |
Nourozian J, Etebarian H R and Khodakaramian G. Biological control of Fusarium graminearum on wheat by antagonistic bacteria[J]. Songklanakarin Journal of Science and Technology, 2006, 28(Suppl.1): 29-38 (  0) 0) |
| [13] |
生防芽孢杆菌的应用研究进展[J]. 西北农林科技大学学报(自然科学版), 2014, 42(8): 185-190 (  0) 0) |
| [14] |
Jamal Q, Cho J Y, Moon J H, et al. Purification and antifungal characterization of Cyclo (D-Pro-L- Val) from Bacillus amyloliquefaciens Y1 against Fusarium graminearum to control head blight in wheat[J]. Biocatalysis and Agricultural Biotechnology, 2017, 10: 141-147 DOI:10.1016/j.bcab.2017.01.003 (  0) 0) |
| [15] |
Trail F. For blighted waves of grain: Fusarium graminearum in the postgenomics era[J]. Plant Physiology, 2009, 149(1): 103-110 DOI:10.1104/pp.108.129684 (  0) 0) |
| [16] |
Leplat J, Friberg H, Abid M, et al. Survival of Fusarium graminearum, the causal agent of Fusarium head blight. A review[J]. Agronomy for Sustainable Development, 2013, 33(1): 97-111 DOI:10.1007/s13593-012-0098-5 (  0) 0) |
| [17] |
土壤农业化学分析方法[M].
中国农业科技出版社, 北京, 2000
(  0) 0) |
| [18] |
Dyer R B, Kendra D F, Brown D W. Real-time PCR assay to quantify Fusarium graminearum wild-type and recombinant mutant DNA in plant material[J]. Journal of Microbiological Methods, 2006, 67(3): 534-542 DOI:10.1016/j.mimet.2006.05.011 (  0) 0) |
| [19] |
Li Z Q, Ma L, Zhang Y, et al. Effect of wheat cultivars with different resistance to Fusarium head blight on rhizosphere Fusarium graminearum abundance and microbial community composition[J]. Plant and Soil, 2020, 448(1/2): 383-397 DOI:10.1007/s11104-020-04441-3 (  0) 0) |
| [20] |
Jones C A. Estimation of an active fraction of soil nitrogen[J]. Communications in Soil Science and Plant Analysis, 1984, 15(1): 23-32 DOI:10.1080/00103628409367451 (  0) 0) |
| [21] |
定殖植物根内和根围放线菌的分离鉴定及其体外抑菌促生效应[J]. 微生物学报, 2019, 59(10): 2024-2037 (  0) 0) |
| [22] |
Li J, Duan Y B, Bian C H, et al. Effects of validamycin in controlling Fusarium head blight caused by Fusarium graminearum: Inhibition of DON biosynthesis and induction of host resistance[J]. Pesticide Biochemistry and Physiology, 2019, 153: 152-160 DOI:10.1016/j.pestbp.2018.11.012 (  0) 0) |
| [23] |
蜡状芽孢杆菌次生代谢产物的研究进展[J]. 农药, 2013, 52(3): 162-164, 170 (  0) 0) |
| [24] |
烟草黑胫病拮抗细菌复合菌株的筛选与防治效果评价[J]. 中国农学通报, 2015, 31(8): 102-107 (  0) 0) |
| [25] |
Inam-Ul-ha M, Javed N, Ahmad R, et al. Evaluation of different strains of Pseudomonas fluorescens for the biocontrol of Fusarium wilt of chickpea[J]. Plant Pathology Journal, 2003, 2(1): 65-74 DOI:10.3923/ppj.2003.65.74 (  0) 0) |
| [26] |
Parnell J J, Berka R, Young H A, et al. From the lab to the farm: An industrial perspective of plant beneficial microorganisms[J]. Frontiers in Plant Science, 2016, 7: 1110 (  0) 0) |
| [27] |
水稻纹枯病菌拮抗细菌的筛选及鉴定[J]. 植物保护学报, 2013, 40(3): 211-218 (  0) 0) |
| [28] |
Lu Z X, Tu G P, Zhang T, et al. Screening of antagonistic Trichoderma strains and their application for controlling stalk rot in maize[J]. Journal of Integrative Agriculture, 2020, 19(1): 145-152 DOI:10.1016/S2095-3119(19)62734-6 (  0) 0) |
| [29] |
Xu W H, Wang K X, Wang H X, et al. Evaluation of the biocontrol potential of Bacillus sp. WB against Fusarium oxysporum f. sp. niveum[J]. Biological Control, 2020, 147: 104288 DOI:10.1016/j.biocontrol.2020.104288 (  0) 0) |
| [30] |
Weller D M. Biological control of soilborne plant pathogens in the rhizosphere with bacteria[J]. Annual Review of Phytopathology, 1988, 26(1): 379-407 (  0) 0) |
| [31] |
潮土中残留小麦和玉米秸秆养分含量差异及与微生物群落组成的关系[J]. 土壤, 2021, 53(1): 55-63 (  0) 0) |
| [32] |
Sun E H, Zhang Y, Yong C, et al. Biological fermentation pretreatment accelerated the depolymerization of straw fiber and its mechanical properties as raw material for mulch film[J]. Journal of Cleaner Production, 2021, 284: 124688 (  0) 0) |
| [33] |
周淑霞. 一种含链霉菌的腐熟菌剂在麦秸还田中的初步应用研究[D]. 南京: 南京师范大学, 2013.
(  0) 0) |
| [34] |
Han D D, Wang L Y, Luo Y P. Isolation, identification, and the growth promoting effects of two antagonistic actinomycete strains from the rhizosphere of Mikania micrantha Kunth[J]. Microbiological Research, 2018, 208: 1-11 (  0) 0) |
| [35] |
Dai Z M, Enders A, Rodrigues J L M, et al. Soil fungal taxonomic and functional community composition as affected by biochar properties[J]. Soil Biology and Biochemistry, 2018, 126: 159-167 (  0) 0) |
| [36] |
长期施肥潮土在玉米季施肥初期的有机碳矿化过程研究[J]. 土壤, 2009, 41(5): 719-725 (  0) 0) |
2. University of Chinese Academy of Sciences, Beijing 100049, China
 2022, Vol. 54
2022, Vol. 54


